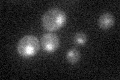
YGL151W
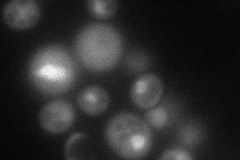
YGL151W
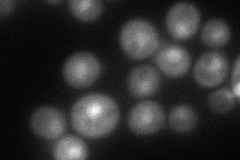
YGL151W
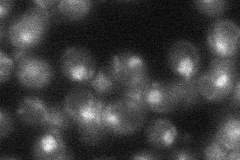
YGL151W

View description
Component of the RNA polymerase II mediator complex, which is required for transcriptional activation and also has a role in basal transcription
Localization:
Intensity:
Fold change:
Significance:
-
C’ GFP library in SD
nucleus19.32 -
N' NOP1pr-GFP in SD
cytosol,nucleus70.0503 -
N' TEF2pr-mCherry in SD
nucleus59.4187 -
N' NATIVEpr-GFP in SD
nucleus25.8301 -
N' TEF2pr-VC and Cyto-VN in SD

#N/A0 -
C’ GFP library in SD+DTT

nucleus19.030.98No -
C’ GFP library in SD+H2O2

nucleus22.011.13No -
C’ GFP library in Starvation Media

nucleus15.830.81No -
C’ GFP library on the background of Pup2-DaMP

N/A -
C’ GFP library on the background of CCT mutant

N/A0N/AYes
